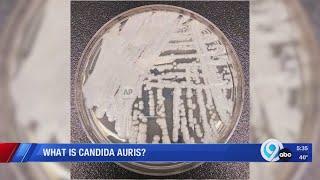

Candida Auris
Oregon Health Authority investigating two Candida Auris fungus infections.
KGW News
556
1,853
3 года назад
Everything you need to know about Candida auris, an infectious fungus
Palm Beach Gardens Medical Center
3K
8,923
1 год назад
Сейчас ищут
Candida Auris
다이바이Tv
Chad Armes
Pandemic
Florian Tufallari
Jordi Koalitic
大陸
Leilang Electrical
Frauen In Der Wirtschaft
Carbon Emissions
Headnodgospel
Xhoundishx
壹加壹
1Ice Cake
Photography Save Money
Beatriz Z
Jarred Anthony
Wishlistwb
Kiki Shortdrama
Глав Врач
Reign Of Supermen
Prince Zohaib
Kuzma671Highlights
The Man Talk Podcast
Particle
Алтайский Край Глазами Подмосквички
Photography For Enjoyment
Латвия
Jesse Speaks
Poco F6 Pro 5G
Kv
Complete Story
Candida Auris. Смотреть видео: What Is Candida Auris, Tom Chiller MD Clinical Overview Of Candida Auris, Candida Auris What Is It Can We Stop It ARC IPC, Candida Auris.